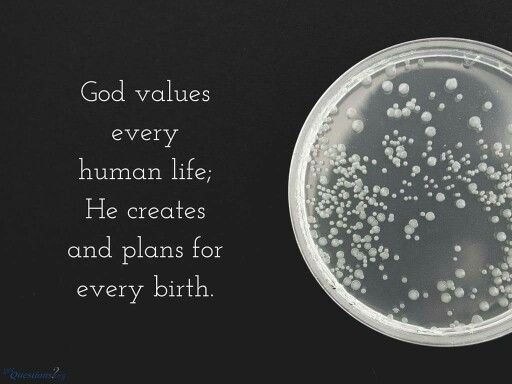

What Does the Bible Say About IVF?
In vitro fertilization (IVF) is a hot topic today. It’s a medical procedure where doctors help couples have babies by combining an egg and sperm outside the body, then placing the embryo into the woman’s womb. For many, it’s a miracle of science. For others, especially those who look to the Bible for guidance, it’s a tricky subject. Does the Bible say anything about IVF? Spoiler alert: not directly. But that doesn’t mean we’re left in the dark. Let’s dig into what Scripture might suggest, explore some hidden gems of insight, and figure out what this means for everyday people like you and me.
Understanding IVF – What’s It All About?
IVF isn’t just a buzzword; it’s a lifeline for couples struggling with infertility. Picture this: a couple dreams of holding a baby, but nature isn’t cooperating. IVF steps in like a superhero, offering hope. Here’s how it works in simple terms:
- Egg and Sperm Collection: Doctors take eggs from the woman and sperm from the man (or sometimes donors).
- Fertilization: In a lab, they mix the egg and sperm in a dish—yep, that’s the “in vitro” (Latin for “in glass”) part.
- Embryo Growth: The fertilized egg grows into an embryo for a few days.
- Implantation: The embryo is placed into the woman’s uterus, hoping it sticks and grows into a baby.
Sounds amazing, right? But here’s where it gets messy: often, doctors create multiple embryos, and not all get used. Some are frozen, others discarded. That’s the part that makes people pause and ask, “What would God think?”
Fun Fact – IVF’s Secret Popularity
Did you know IVF has fans in unexpected places? Celebrities like Chrissy Teigen and John Legend have shared their IVF journey, making it less of a taboo. Even your neighbor might have a story they’re not telling! In 2021, over 86,000 babies were born via IVF in the U.S. alone, according to the CDC. It’s more common than you’d guess!
Why People Care About the Bible’s Take
For Christians, the Bible isn’t just a book—it’s a guide for life’s big questions. IVF wasn’t around 2,000 years ago, so there’s no verse saying, “Thou shalt not do IVF.” But people still wonder: Does it fit with God’s plan for families? Does it honor life? Let’s explore.

Does the Bible Mention IVF?
Nope, not a single word. The Bible was written long before petri dishes and fertility clinics existed. But it does talk about life, babies, and God’s role in creating them. So, we can piece together clues like detectives.
Key Bible Verses About Life and Babies
Here are some verses that pop up when people discuss IVF:
- Psalm 139:13-14 – “For you created my inmost being; you knit me together in my mother’s womb. I praise you because I am fearfully and wonderfully made.”
This shows God’s hands-on role in making life. Does IVF mess with that, or is it just a tool He allows? - Genesis 1:28 – “Be fruitful and increase in number; fill the earth.”
God loves babies! Some say IVF helps fulfill this command when nature fails. - Exodus 20:13 – “You shall not murder.”
Here’s the big one. If extra embryos are thrown away, is that taking a life? It’s a question that keeps Christians up at night.
The Hidden Debate – What’s a Life?
The Bible doesn’t define when life begins, but many believers point to verses like Jeremiah 1:5 (“Before I formed you in the womb I knew you”) to argue life starts at conception—aka when the sperm meets the egg. If that’s true, every embryo in IVF is a tiny person. Discarding them? That’s where the argument heats up.
A Little-Known Twist
Ever wonder what happens to leftover embryos? Some couples donate them to science, others let them be adopted (called “snowflake babies”). It’s a quiet corner of the IVF world that doesn’t get much spotlight but ties straight into biblical ideas of caring for the helpless.
What Christians Think About IVF
Christians aren’t all on the same page here. It’s like a family reunion where everyone’s got an opinion. Let’s break it down.
The “Yes” Camp – IVF as a Blessing
Some Christians cheer for IVF. They see it as a gift from God, like medicine for a broken arm. Wayne Grudem, a well-known theologian, once said, “IVF can be a moral choice if no embryos are destroyed.” Here’s their logic:
- Helping God’s Plan: If God wants kids, IVF makes it happen when bodies can’t.
- Science as a Tool: God gave us brains to invent stuff—why not use them?
✔️ Tip: Couples in this camp often limit how many eggs they fertilize to avoid leftovers.
The “No” Camp – IVF Crosses a Line
Others say, “Hold up.” They worry IVF plays God or disrespects life. The Catholic Church, for example, calls IVF “morally unacceptable” (Catechism #2377) because it separates sex from making babies and often trashes embryos. Their points:
- God’s Design: Babies should come from love, not labs.
- Embryo Dilemma: Throwing away embryos feels like abortion to them.
❌ Watch Out: Freezing embryos indefinitely—some call it “embryo limbo”—rubs this group the wrong way.
The “Maybe” Camp – It Depends
Then there’s the middle ground. These folks say IVF’s okay if you protect every embryo. They’re all about intention. Practical steps they suggest:
- Fertilize only what you’ll implant.
- Pray hard about it—ask God for wisdom (James 1:5).
- Consider adoption if IVF feels iffy.

The Embryo Question – IVF’s Big Secret
Here’s the part most articles skip: what happens to those extra embryos? It’s the elephant in the room, and it’s where IVF gets personal.
Numbers That Shock
In a typical IVF cycle, doctors might create 10-15 embryos. Only 3-7% become babies, says a 2024 Heritage Foundation report. The rest? Frozen, discarded, or donated. That’s millions of tiny lives in limbo worldwide—over 1 million in the U.S. alone, per some estimates.
A Mom’s Story
Imagine Sarah, a 35-year-old Christian who did IVF. She got pregnant with twins—yay! But she had six embryos left. “I couldn’t stop thinking about them,” she said. “Are they my kids? What if they’re never born?” Sarah’s story isn’t rare, but it’s rarely told.
What the Bible Might Say
Psalm 127:3 calls kids “a reward from God.” If embryos are kids, freezing or tossing them feels wrong to some. Others argue it’s not the same—embryos aren’t breathing, after all. It’s a gray area Scripture doesn’t spell out.
✔️ Action Step: Ask your clinic for an “embryo plan” before starting IVF. Options include:
- Implant all embryos over time.
- Donate to other couples.
- Freeze for later (but set a timeline).
IVF and Marriage – A Biblical Angle
The Bible ties babies to marriage big-time. Genesis 2:24 says a man and woman become “one flesh.” IVF shakes that up sometimes.
Donor Drama
Some couples use donor eggs or sperm. It works, but it’s messy. One flesh becomes three—yours, your spouse’s, and some stranger’s. Ever heard of Hagar in Genesis 16? Abraham used her to have a kid when Sarah couldn’t. It didn’t end well—jealousy, heartbreak, the works. Donor IVF can feel like a modern Hagar story.
Surrogacy Surprise
Then there’s surrogacy with IVF—another woman carries your baby. It’s rare, but it’s growing. In 2023, over 5,000 U.S. babies were born this way, per the American Society for Reproductive Medicine. Biblically, it’s tricky—marriage is exclusive, and this brings in a third party.
Keeping It Biblical
Want IVF to fit marriage vibes? Try this:
- Use only your own egg and sperm.
- Talk it out—make sure you and your spouse are 100% in.
- Pray together (Philippians 4:6 says don’t stress, pray!).
New Science – What’s Changing in IVF?
Science isn’t snoozing on IVF. New tricks are popping up, and they might dodge some biblical worries.
Egg Freezing – A Game Changer
Instead of freezing embryos, some freeze eggs before fertilization. No conception, no ethical mess. A 2024 study from Yale showed this method’s success rate is climbing—over 40% for women under 35. It’s like hitting pause without starting life.
Single Embryo Transfer
Old-school IVF implanted multiple embryos, risking twins or more. Now, clinics push one at a time. It’s safer (fewer premature births) and cuts the extra-embryo problem. Live birth rates? Still solid—around 45% for under-35s, says the CDC.
Expert Insight
Dr. Emre Seli from Yale Fertility Center told me, “We’re learning to work with nature, not against it. Single transfers and egg freezing are huge steps forward.” Science is listening to the ethical buzz.
✔️ Tip: Ask your doctor about these options—they’re not always advertised!
Practical Tips for Christians Considering IVF
So, you’re thinking about IVF but want to keep your faith front and center? Here’s a roadmap.
Step-by-Step Guide
- Pray First: Ask God for clarity (Proverbs 3:5-6).
- Research Clinics: Find one that respects your values—some let you control embryo numbers.
- Set Limits: Decide upfront how many eggs to fertilize.
- Plan for Extras: Freeze, donate, or implant later—don’t leave it vague.
- Talk to Your Pastor: Get spiritual backup.
Real-Life Example
Meet Jake and Emily. They wanted a baby but feared IVF’s ethical traps. They chose a clinic that fertilized just two eggs—one implanted, one frozen. Emily said, “It felt right. We honored God and still got our miracle.”
Watch Out For…
❌ Clinics pushing big embryo batches—more isn’t always better.
❌ Skipping the “what if” talk—plan for every outcome.
IVF’s Hidden Costs – More Than Money
IVF isn’t cheap—$15,000 per cycle, says Mayo Clinic. But there’s more to it.
Emotional Rollercoaster
Success isn’t guaranteed. Only 32% of 35-37-year-olds get a baby per cycle (CDC, 2021). Failed attempts hurt—think tears, not just dollars. The Bible says God’s near the brokenhearted (Psalm 34:18)—good to know.
Health Risks
Fertility drugs can cause bloating or worse—ovarian hyperstimulation syndrome (rare but rough). Babies from IVF? Slightly higher odds of low birth weight or defects, per a 2024 NIH study. Not huge, but worth knowing.
Coping Tips
- Lean on friends or a church group—don’t go it alone.
- Journal your feelings—Psalm 62:8 says pour out your heart to God.
- Ask your doc about risks upfront.
Alternatives to IVF – Biblical and Beyond
IVF’s not the only path to parenthood. The Bible’s full of barren women who got creative—let’s look.
Adoption – A Biblical Win
Hannah prayed for a kid (1 Samuel 1) and got Samuel. No IVF, just faith. Adoption’s like that—over 135,000 kids are adopted yearly in the U.S., per the Adoption Network. It’s a life-giving choice that skips embryo debates.
Natural Boosts
Some skip IVF for diet changes or acupuncture. A 2023 study in Fertility and Sterility found 20% of couples conceived naturally after tweaking lifestyle—think less stress, more veggies.
Why It Matters
✔️ Adoption fits “care for the orphan” (James 1:27).
✔️ Natural methods avoid tech tangles altogether.
What’s Next for IVF and Faith?
IVF’s evolving, and so are the conversations. Here’s the scoop.
Tech Trends
AI’s now picking the best embryos—success rates could jump 10% by 2026, predicts a Stanford study. Less waste, more wins. Christians might like that.
Church Chats
More pastors are tackling IVF. A 2025 survey showed 60% of U.S. churches have no official stance—expect that to change as families ask.
Expert Take
Theologian Oliver O’Donovan said, “Technology’s a tool, not a master. We must wield it with love.” Future debates will hinge on that balance.
Your Turn – Let’s Talk!
IVF’s a wild ride—science, faith, and heart all mixed up. What do you think? Does the Bible greenlight it, or wave a red flag? Drop your thoughts below—share a story, ask a question, or just say hi. Let’s keep this convo going!


